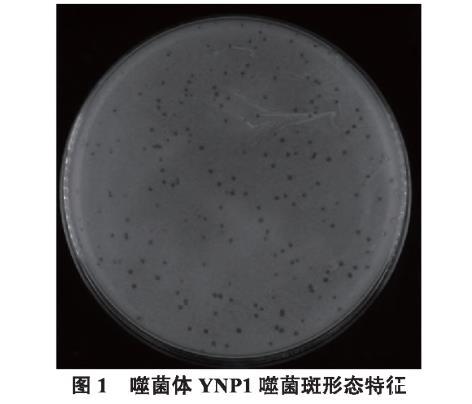

高效裂解多重耐药金黄色葡萄球菌噬菌体YNP1生物学特性研究(二)
1.7 噬菌体基因组测序和裂解酶基因的挖掘
提取噬菌体的基因组,送至上海派森诺生物科技有限公司进行基因组测序。使用PHAST软件和NCBI BLAST软件对噬菌体全基因组序列进行分析,挖掘潜在的裂解酶基因来进行深入研究。
1.8 噬菌体裂解酶的表达及纯化
1.8.1 裂解酶基因lysYNP1的克隆
根据获得的裂解酶基因序列设计引物,并在两条引物的5'端插入pET28a连接接头(如下划线所示)。F:5'-GGTACCCTCGAGGGATCCATGGCTAAGACTCAAGCAGAA-3';R:5'-CTGCAGGTCGACAAGCTTTAACTCTTGAATGTCCCCCA-3'。PCR反应体系:上、下游引物各2 μL,噬菌体YNP1基因组2 μL,PrimeSTAR Max Premix(2)25 μL,ddH2O 19 μL。PCR反应条件:98℃预变性3 min;98℃变性10 s,55℃退火15 s,72℃延伸15 s,30个循环;72℃延伸5 min。反应结束后,将产物采用1%的琼脂糖凝胶电泳检测,并用胶回收试剂盒回收PCR产物。
1.8.2 表达载体的构建
利用Hieff Clone® Plus One Step Cloning Kit一步法快速克隆试剂盒构建裂解酶pET28a表达载体,方法如下:首先将pET28a进行酶切线性化处理,酶切体系:BamH I 1 μL、Hind III 1 μL、pET28a 3 μL、10×Buffer 5 μL、ddH2O 40 μL,30℃、15 min,37℃、20 min酶切;随后将1.8.1回收的裂解酶基因连接至线性化的pET28a载体,连接体系为:2×Hieff Clone Enzyme Premix 5 μL、酶切后pET28a质粒2 μL、回收的裂解酶基因1 μL、ddH2O 2 μL,50℃连接20 min。将连接产物转化至BL21感受态细胞,涂板,过夜培养,并将筛选到的阳性克隆送去测序。将比对成功的质粒,转化到大肠杆菌BL21。
1.8.3 裂解酶LysYNP1的表达
将构建好的裂解酶表达菌株按1∶100的比例接种于含有卡那抗性的LB液体培养基中,在37℃摇床200 rpm振荡培养至对数期(OD600约0.6)。然后加入IPTG至终浓度为1 mmol/L,25℃、120 rpm摇床过夜诱导表达。并于诱导前和诱导后各取菌液1 mL,诱导后的1 mL菌液进行破碎,破碎后的沉淀用1 mL的PBS重悬,分别取诱导前菌液、诱导后上清液、诱导后沉淀各50 μL,煮沸后进行10% SDS-PAGE电泳。剩余菌液于4℃、2796×g离心20 min,弃去上清液,25 mL PBS重悬后洗3次,加入25 mL PBS重悬后超声破碎,4℃条件下7157×g离心20 min后取上清液用0.45 μm滤膜过滤后获得裂解酶LysYNP1粗提液,于4℃保存。
1.8.4 裂解酶LysYNP1的活性检测以及裂菌谱的测定
现采用丹麦Biosense公司oCelloScope系统定量评估裂解酶活性。将不同浓度的裂解酶粗提液与过夜培养的宿主菌液混合加入检测板,系统自动监测并记录细菌浓度(生物量)的实时变化。通过比较加酶组与对照组(PBS)细菌生长/裂解曲线的差异,可量化裂解酶的杀菌动力学和裂解效率,并生成剂量-效应曲线。
2 结果
2.1 噬菌体的分离与鉴定
2.1.1 噬菌体分离及噬菌斑形态
污水样本过滤上清液与指示菌混合经双层琼脂平板法测定和纯化,37℃培养12h后,在平板上能形成明显噬菌斑。噬菌斑呈圆形、大而透明、边缘整齐(图1)。经双层琼脂平板法测定噬菌体效价为109 PFU/mL。
图1 噬菌体YNP1噬菌斑形态特征
2.1.2 噬菌体的电镜观察
纯化的噬菌体经磷钨酸负染后,在120 kV透射电镜下观察其形态(图2)。噬菌体的头部呈二十面体立体对称,头部直径约100 nm,含有收缩性尾部,尾部的末端具有清晰的尾丝,并且暴露出尾管,尾部长约125 nm,宽约25 nm。根据2012年国际病毒分类委员会第9次报告提出的噬菌体分类与命名标准,该噬菌体符合肌尾噬菌体科特征,命名为vB_SauM_YNP1。

图2 噬菌体YNP1电镜照片
2.2 噬菌体的生物学特性
2.2.1 裂菌谱的测定
通过平板裂解实验及斑点实验检测噬菌体对实验菌株的裂解效果。结果发现,该噬菌体对金黄色葡萄球菌菌株B52、05Q132、JY-1、JY-2、JY-3、JY-4和DL57-2具有极强的裂解效果,形成明显的裂菌圈。对大肠杆菌O157菌株Min27、K-12菌株MC1061以及猪链球菌HA9801和无乳链球菌ATCC13813均没有明显的裂解效果(表1)。
| 菌株类型 | 菌株编号 | 双层琼脂平板实验 | 斑点实验 |
|---|---|---|---|
| 耐甲氧西林金黄色葡萄球菌(5株) | B52 | - | + |
| 05Q132 | - | + | |
| DL57-2 | - | + | |
| 361 | - | + | |
| 439 | - | + | |
| 临床分离的多重耐药金黄色葡萄球菌(9株) | JY-1 | - | + |
| JY-2 | - | + | |
| JY-3 | - | + | |
| JY-4 | - | + | |
| JY-5 | - | + | |
| JY-6 | - | + | |
| JY-7 | - | + | |
| JY-8 | - | - | |
| JY-9 | - | - | |
| 临床分离多重耐药松鼠葡萄球菌 | SH-1 | - | + |
| 临床分离多重耐药其他葡萄球菌 | SH-2 | - | + |
| 临床分离多重耐药人葡萄球菌 | SH-3 | - | + |
| 临床分离多重耐药鸡葡萄球菌 | SH-4 | - | + |
| 大肠杆菌(2株) | Min27 | - | - |
| MC1061 | - | - | |
| 无乳链球菌(1株) | ATCC13813 | - | - |
| 猪链球菌(1株) | HA9801 | - | - |
| 注:“+”:裂解性;“-”:不裂解 | |||
注:“+”:裂解;“-”:不裂解。
2.2.2 噬菌体的热稳定性测定
噬菌体在30℃~75℃水浴条件下作用1h后的滴度变化如图3A所示,在30℃~55℃时,噬菌体能保持活性,而随着温度升高,噬菌体的效价也会迅速下降,到60℃时噬菌体完全失活。
2.2.3 噬菌体的pH稳定性测定
噬菌体在pH2.0~13.0各培养1h后噬菌体的滴度变化如图3B所示,在pH4.0~10.0时,噬菌体能维持较好的活性,当pH过高或过低,噬菌体的滴度会明显下降。当pH为2和12时,噬菌体完全失活。表明该噬菌体具有良好的酸碱耐受性。
2.2.4 噬菌体对紫外线的敏感性
噬菌体经紫外线处理不同时间后,测定噬菌体效价。结果显示,在紫外线照射30min后,噬菌体效价急剧下降,随着时间的延长,噬菌体的存活率下降幅度变缓(图3C)。

2.2.5 噬菌体对氯仿的敏感性
噬菌体经不同比例的氯仿处理,孵育30min后检测噬菌体滴度。结果显示,噬菌体效价由4.60×109 PFU/mL下降到1.72×109 PFU/mL(图3D),表明该噬菌体对氯仿不敏感,即该噬菌体无囊膜。
相关新闻推荐
1、不同温度和pH对白三叶草链格孢菌菌落生长的影响【实验结果】
2、E-test法多黏菌素药敏条用于临床肠杆菌科体外药敏检测(一)
